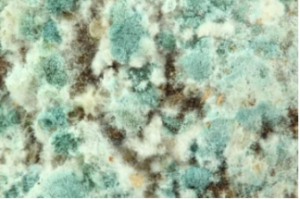
Mahwah NJ - Exposure To VOCs Can Affect Health

What Are Vocs?
VOCs are Volatile Organic Compounds. These are chemicals produced in the manufacture of paints, some pharmaceutical products and refrigerants. Generally the concentration of VOCs will be higher indoors than outdoors, at times as much as 10 times higher. You and your family may be getting exposed to high pollutant levels which are a health risk. This occurs with the use of products that contain organic chemicals.
pharmaceutical products and refrigerants. Generally the concentration of VOCs will be higher indoors than outdoors, at times as much as 10 times higher. You and your family may be getting exposed to high pollutant levels which are a health risk. This occurs with the use of products that contain organic chemicals.
Mold Testing NJ-NY is a certified Indoor Air Quality inspector, serving the Bergen County NJ area as well as surrounding northern NJ counties and some NYS counties. We inspect and can determine the presence and level of VOCs in your home.
What Products Emit VOCs?
Some products that emit VOCs are:
- paints and varnishes
- wax
- cleaning and disinfecting agents
- some cosmetics
- degreasing agents
- hobby products
- fuels
- pesticides
How Is One’s Health Affected by VOCs
As with all polluting agents, negative health effects produced by VOCs depend on the level and length of exposure to them. Some of the symptoms resulting from exposure to VOCs, and all of which can lead to more serious illness are:
- Eye irritation and eyesight problems
- Respiratory irritation
- Headaches
- Dizziness
- Memory impairment
Prevention Of Exposure To VOCs
Some ways of reducing your exposure to harmful chemicals in the air are:
Keep your home well ventilated, especially when using products that release pollutants
Be sure to read labels on products that may emit VOCs and follow the manufacturer’s instructions about use, clean-up and storage.
Of couse, keep VOC-emitting products out of the reach of children.
The EPA website is a useful resource for you to do some research regarding VOC-emitting products. Check it out when beginning a project that requires their use.
Indoor Air Quality Inspection Is Recommended
Mold Testing NJ-NY is a licensed and experienced Indoor Air Quality inspector. We inspect, test and advise a client about Air Quality issues. We do not remediate, but we will recommend remediation if deemed necessary. To learn about our inspection process and the benefits offered to you and your family, call us at (201) 658-8881.





